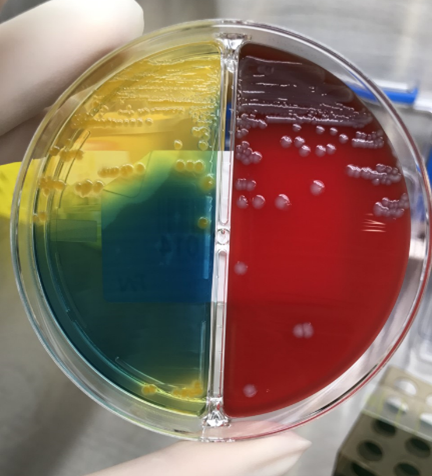

検査部診療科・部門案内一覧へ戻る
感染症検査
血液、喀痰、尿や便などから病原微生物を検出し、どの薬が有効であるかを調べる検査です。
.
顕微鏡検査
喀痰や尿などを直接スライドガラスに塗り、染色をした後顕微鏡で観察します。
_l.png)
※写真は尿検体です。染色をして 白血球や菌を見つけます。
丸い細胞が白血球で、棒状に見えるものは大腸菌です。
丸い細胞が白血球で、棒状に見えるものは大腸菌です。
.
培養検査
喀痰や尿などから病原菌を目に見える菌塊とするために、様々な種類の寒天培地に塗り広げ時間をかけて発育させます。
- 大腸菌です
.
同定検査・薬剤感受性検査
発育してきた病原菌がどのような菌なのか、どういった薬が効くのかを調べます。

.
遺伝子検査
上記の培養検査や同定検査などは菌塊を発育させるために数日かかってしまいます。
遺伝子検査は迅速かつ高感度に病原菌を検出できるため、新型コロナウイルスの流行を機に、多くの施設で導入されました。
遺伝子検査は迅速かつ高感度に病原菌を検出できるため、新型コロナウイルスの流行を機に、多くの施設で導入されました。
.
チーム活動
ICT(Infection Control Team)として患者さんや職員を院内感染から守る活動を行っています。AST(Antimicrobial Stewardship Team)では抗菌薬の適正使用を推進し、最適な感染症治療を行うとともに、耐性菌を抑制する活動を行っています。
.
認定臨床微生物検査技師制度研修施設

当院は、認定臨床微生物検査技師制度研修施設の認定を受けています。



